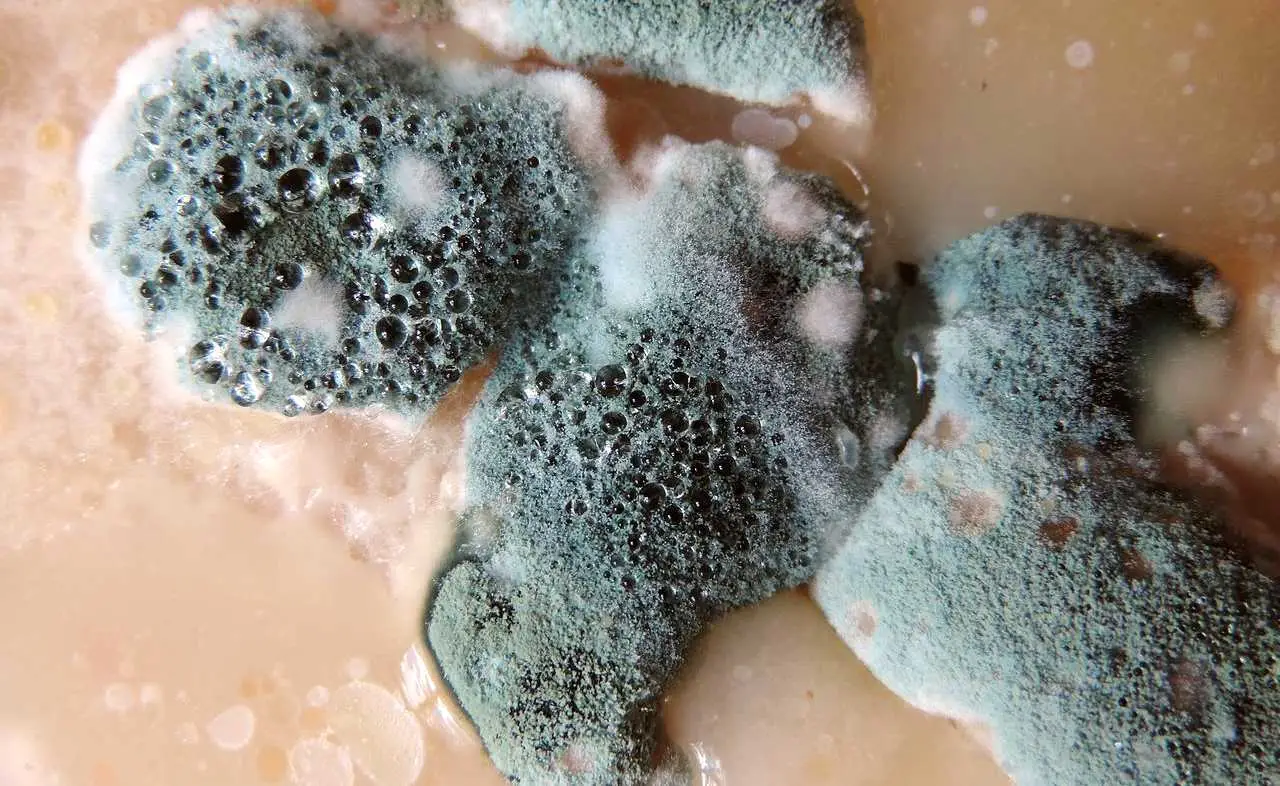
A quale grado di umidità si forma la muffa? Ecco la risposta

Allarme infestazioni: ecco quando basta il fai da te e quando serve la disinfestazione professionale
Quando in casa o nei luoghi di lavoro si verifica la presenza di parassiti, insetti o roditori, la prima reazione di molte persone è cercare una soluzione rapida e autonoma. Spesso il fai da te viene considerato sufficiente, almeno nelle fasi iniziali, per eliminare qualche insetto isolato o risolvere apparenti piccoli problemi. Tuttavia, esistono situazioni … Leggi tutto